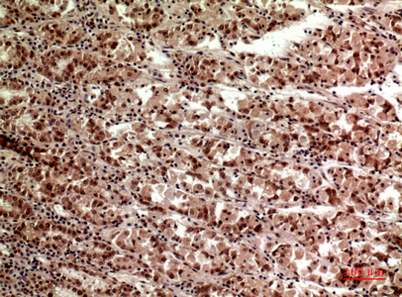

TERT rabbit pAb
 One-click to copy product information
One-click to copy product information$148.00/50µL $248.00/100µL
| 50 µL | $148.00 |
| 100 µL | $248.00 |
Overview
| Product name: | TERT rabbit pAb |
| Reactivity: | Human;Rat;Mouse; |
| Alternative Names: | TERT; EST2; TCS1; TRT; Telomerase reverse transcriptase; HEST2; Telomerase catalytic subunit; Telomerase-associated protein 2; TP2 |
| Source: | Rabbit |
| Dilutions: | Western Blot: 1/500 - 1/2000. IHC-p: 1/100-1/300. ELISA: 1/20000. Not yet tested in other applications. |
| Immunogen: | The antiserum was produced against synthesized peptide derived from the C-terminal region of human TERT. AA range:931-980 |
| Storage: | -20°C/1 year |
| Clonality: | Polyclonal |
| Isotype: | IgG |
| Concentration: | 1 mg/ml |
| Observed Band: | 130kD |
| GeneID: | 7015 |
| Human Swiss-Prot No: | O14746 |
| Cellular localization: | Nucleus, nucleolus . Nucleus, nucleoplasm. Nucleus. Chromosome, telomere. Cytoplasm. Nucleus, PML body. Shuttling between nuclear and cytoplasm depends on cell cycle, phosphorylation states, transformation and DNA damage. Diffuse localization in the nucleoplasm. Enriched in nucleoli of certain cell types. Translocated to the cytoplasm via nuclear pores in a CRM1/RAN-dependent manner involving oxidative stress-mediated phosphorylation at Tyr-707. Dephosphorylation at this site by SHP2 retains TERT in the nucleus. Translocated to the nucleus by phosphorylation by AKT. |
| Background: | Telomerase is a ribonucleoprotein polymerase that maintains telomere ends by addition of the telomere repeat TTAGGG. The enzyme consists of a protein component with reverse transcriptase activity, encoded by this gene, and an RNA component which serves as a template for the telomere repeat. Telomerase expression plays a role in cellular senescence, as it is normally repressed in postnatal somatic cells resulting in progressive shortening of telomeres. Deregulation of telomerase expression in somatic cells may be involved in oncogenesis. Studies in mouse suggest that telomerase also participates in chromosomal repair, since de novo synthesis of telomere repeats may occur at double-stranded breaks. Alternatively spliced variants encoding different isoforms of telomerase reverse transcriptase have been identified; the full-length sequence of some variants has not been determined. Alternative sp |
-
 Western Blot analysis of HeLa, HepG2 cells using TERT Polyclonal Antibody. Secondary antibody(catalog#:RS0002) was diluted at 1:20000
Western Blot analysis of HeLa, HepG2 cells using TERT Polyclonal Antibody. Secondary antibody(catalog#:RS0002) was diluted at 1:20000 -
 Immunohistochemical analysis of paraffin-embedded human-tonsilla, antibody was diluted at 1:100
Immunohistochemical analysis of paraffin-embedded human-tonsilla, antibody was diluted at 1:100 -
 Immunohistochemical analysis of paraffin-embedded human-stomach, antibody was diluted at 1:100
Immunohistochemical analysis of paraffin-embedded human-stomach, antibody was diluted at 1:100 -
Immunohistochemical analysis of paraffin-embedded human-stomach, antibody was diluted at 1:100
Immunohistochemical analysis of paraffin-embedded human-stomach, antibody was diluted at 1:100

 Manual
Manual